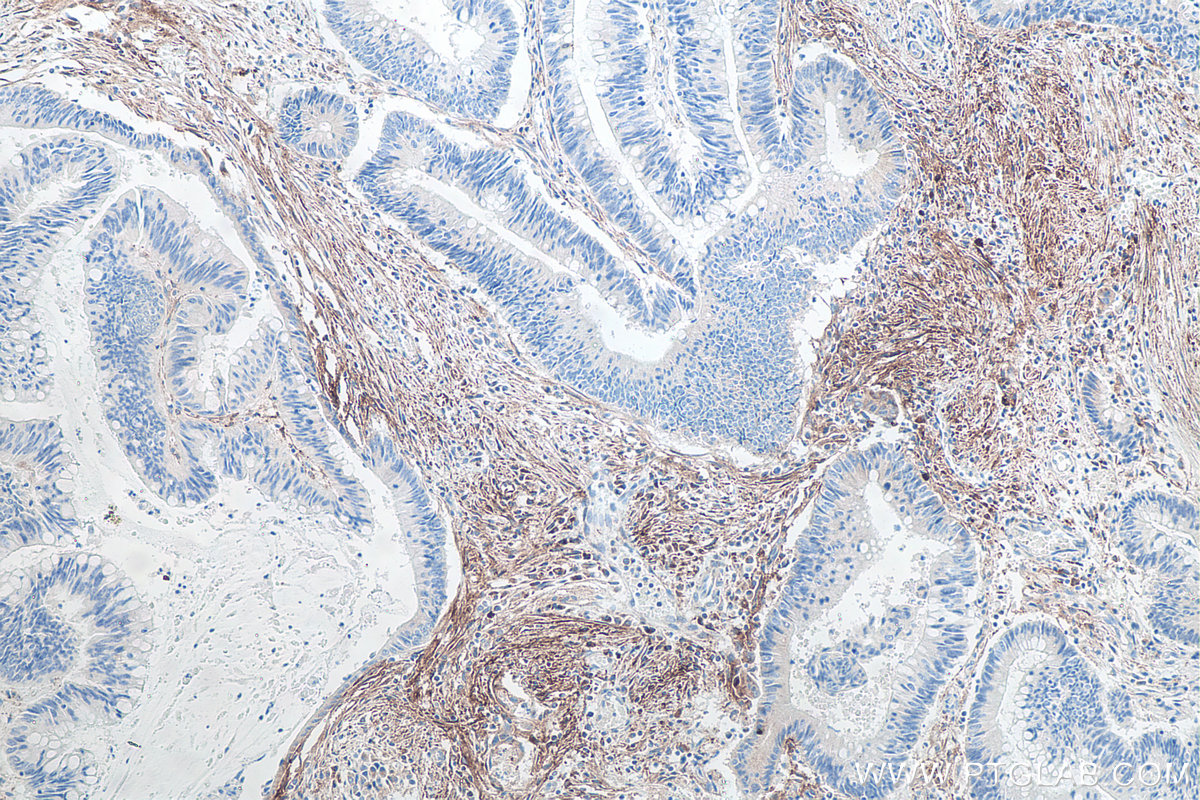

IHCeasy® Podoplanin Ready-To-Use IHC Kit
Podoplanin Ready-to-use reagent kit for IHC.
Reactivity
Human
Sample Type
FFPE tissue
Cat no : KHC0092
Synonyms
AGGRUS, D2 40,M2A, Glycoprotein 36, GP36, Gp38, GP40, HT1A 1, M2A, OTS8, PA2.26, PA2.26 antigen, PDPN, podoplanin, PSEC0025, T1 alpha, T1A, T1A 2
Validation Data Gallery
Product Information
KHC0092 is a ready-to-use IHC kit for staining of Podoplanin (PDPN). The kit provides all reagents, from antigen retrieval to cover slip mounting, that require little to no diluting or handling prior to use. Simply apply the reagents to your sample slide according to the protocol and you're steps away from obtaining high-quality IHC data.
| Product name | IHCeasy Podoplanin Ready-To-Use IHC Kit |
| Sample type | FFPE tissue |
| Assay type | Immunohistochemistry |
| Primary antibody type | Mouse Monoclonal |
| Secondary antibody type | Polymer-HRP-Goat anti-Mouse |
| Reactivity | Human |
Kit components
| Component | Size | Concentration |
|---|---|---|
| Antigen Retrieval Buffer | 100 mL | 50× |
| Washing Buffer | 100 mL ×2 | 20× |
| Blocking Buffer | 5 mL | RTU |
| Primary Antibody | 5 mL | RTU |
| Secondary Antibody | 5 mL | RTU |
| Chromogen Component A | 0.2 mL | RTU |
| Chromogen Component B | 4 mL | RTU |
| Signal Enhancer | 5 mL | RTU |
| Counter Staining Reagent | 5 mL | RTU |
| Mounting Media | 5 mL | RTU |
| Datasheet | 1 Copy | |
| Manual | 1 Copy |
Background Information
Podoplanin (PDPN) was identified as a glycoprotein found in the cell membranes of glomerular epithelial cells (podocyte). It is a lymphatic marker because the expression of podoplanin has been detected in lymphatic but not blood vascular endothelium, and is useful as the marker of tumor-associated lymphangiogenesis. Podoplanin has a function in developing testis, most likely at the level of cell-cell interactions among pre-meiotic germ cells and immature Sertoli cells. It may be involved in cell migration and/or actin cytoskeleton organization. When expressed in keratinocytes, PDPN induces changes in cell morphology with transfected cells showing an elongated shape, numerous membrane protrusions, major reorganization of the actin cytoskeleton, increased motility and decreased cell adhesion. It is required for normal lung cell proliferation and alveolus formation at birth. PDPN induces platelet aggregation. It does not have any effect on folic acid or amino acid transport and does not function as a water channel or as a regulator of aquaporin-type water channels.
Properties
| Storage Instructions | All the reagents are stored at 2-8°C. The kit is stable for 6 months from the date of receipt. |
| Synonyms | AGGRUS, D2 40,M2A, Glycoprotein 36, GP36, Gp38, GP40, HT1A 1, M2A, OTS8, PA2.26, PA2.26 antigen, PDPN, podoplanin, PSEC0025, T1 alpha, T1A, T1A 2 |